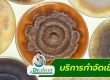

บริการกำจัดหนู (Rats Removal Services)
บริการกำจัดหนู (Rats Removal Services) เพราะว่า หนู เป็นสัตว์แพร่เชื้อโรค เนื่องจากทำให้เกิดการปนเปื้อนในอาหารและน้ำ เช่น ซาลโมเนลลา (Salmonella), เล็ปโตสโปโรสิส (Leptospirosis) หรือโรคฉี่หนู, ไวรัสฮันตา (Hantavirus) และอื่นๆ อีกมาก หรือก่อความเสียหาย ต่อทั้งทรัพย์สิน และเกิดความเสี่ยงต่ออัคคีภัยจากการกัดแทะสายไฟ เป็นต้น
ซึ่งหากว่าท่านอยากไล่หนูด้วยตัวเอง แต่อาจจะไม่สะดวก หรือไม่ได้ผล เราแนะนำให้ใช้บริการจากเรา Dr.ปลวก ให้ช่วยจัดการกำจัดหนูให้ออกจากบ้านท่านได้ ด้วยความเชี่ยวชาญในการให้บริการ มายาวนานกว่า 30 ปี และเราใช้ระบบนาโนเทคโนโลยี (NanoTechnology System) และด้วย ระบบหัวเข็ม (Pin System) ที่ได้มีการพัฒนา และเป็นระบบที่มาจากประเทศอิสราเอล โดยเน้นและคำนึงถึงความปลอดภัยต่อคนและสัตว์เลี้ยงเป็นหลัก พร้อมช่วยรักษาสิ่งแวดล้อม ปลอดภัย ไม่มีสารตกค้าง และมั่นใจว่าเห็นผล 100%
พื้นที่ให้บริการกำจัดหนู ทั่วประเทศไทย เช่น
- กรุงเทพมหานคร
- ปทุมธานี
- สุขุมวิท
- วิภาดี
- ประชาชื่น
- ธนบุรี
- เขตปริมณฑล
- นครปฐม
- นนทบุรี
- สมุทรสาคร
- สมุทรปราการ
- ฉะเชิงเทรา
ทั้งนี้ หากท่านอยู่นอกพื้นที่ดังกล่าว เรายังให้บริการในส่วนของพื้นที่ต่างจังหวัด ท่านสามารถสอบถามรายละเอียดเพิ่มเติมเกี่ยวกับพื้นที่ที่ให้บริการเพิ่มเติมได้

ขั้นตอนการกำจัดหนู
- ใช้น้ำยา สารปลอดภัย ไร้สารพิษ
- ใช้ เครื่องมือถังอัดลม ซึ่งเป็นระบบหัวเข็มฉีด แบบปรับหัวฉีดกระจาย โดยฉีดน้ำยา “สารปลอดภัย” ให้ทั่วบริเวณที่มีกลิ่นสาบหนู ทางเดินหนู โดยสังเกตุจากมูลหนูให้ทั่ว
- “สารปลอดภัย” ซึ่งมีทั้ง ชนิดน้ำและผงบรรจุซอง, น้ำยาชนิดน้ำ เมื่อหนูเดินผ่าน ก็จะโดนทำลายระบบประสาทหนูและก็จะออกจากที่ซ่อนไป, ส่วน ยากำจัดหนูชนิดผงบรรจุซอง ใช้เพื่อให้หนูกินแทนอาหาร ก็จะทำให้หนูเบื่ออาหาร และหนีออกจากแหล่งซ่อนไปสู่ภายนอกบ้านอาคาร แล้วจะค่อยๆจากสถานที่ๆในบริเวณนั้นๆ
- ส่วนการฉีดกำจัดหนู ด้วยการวางผงนาโน ที่มีทั้งชนิดซองและเม็ด ตามจุดต่างที่มี หนู วิ่ง เดินผ่าน และไว้ในที่ๆ ลับตา
- ส่วน สารนาโนเทคโนโลยี จะมีอายุในระยะเวลา 1 ปี